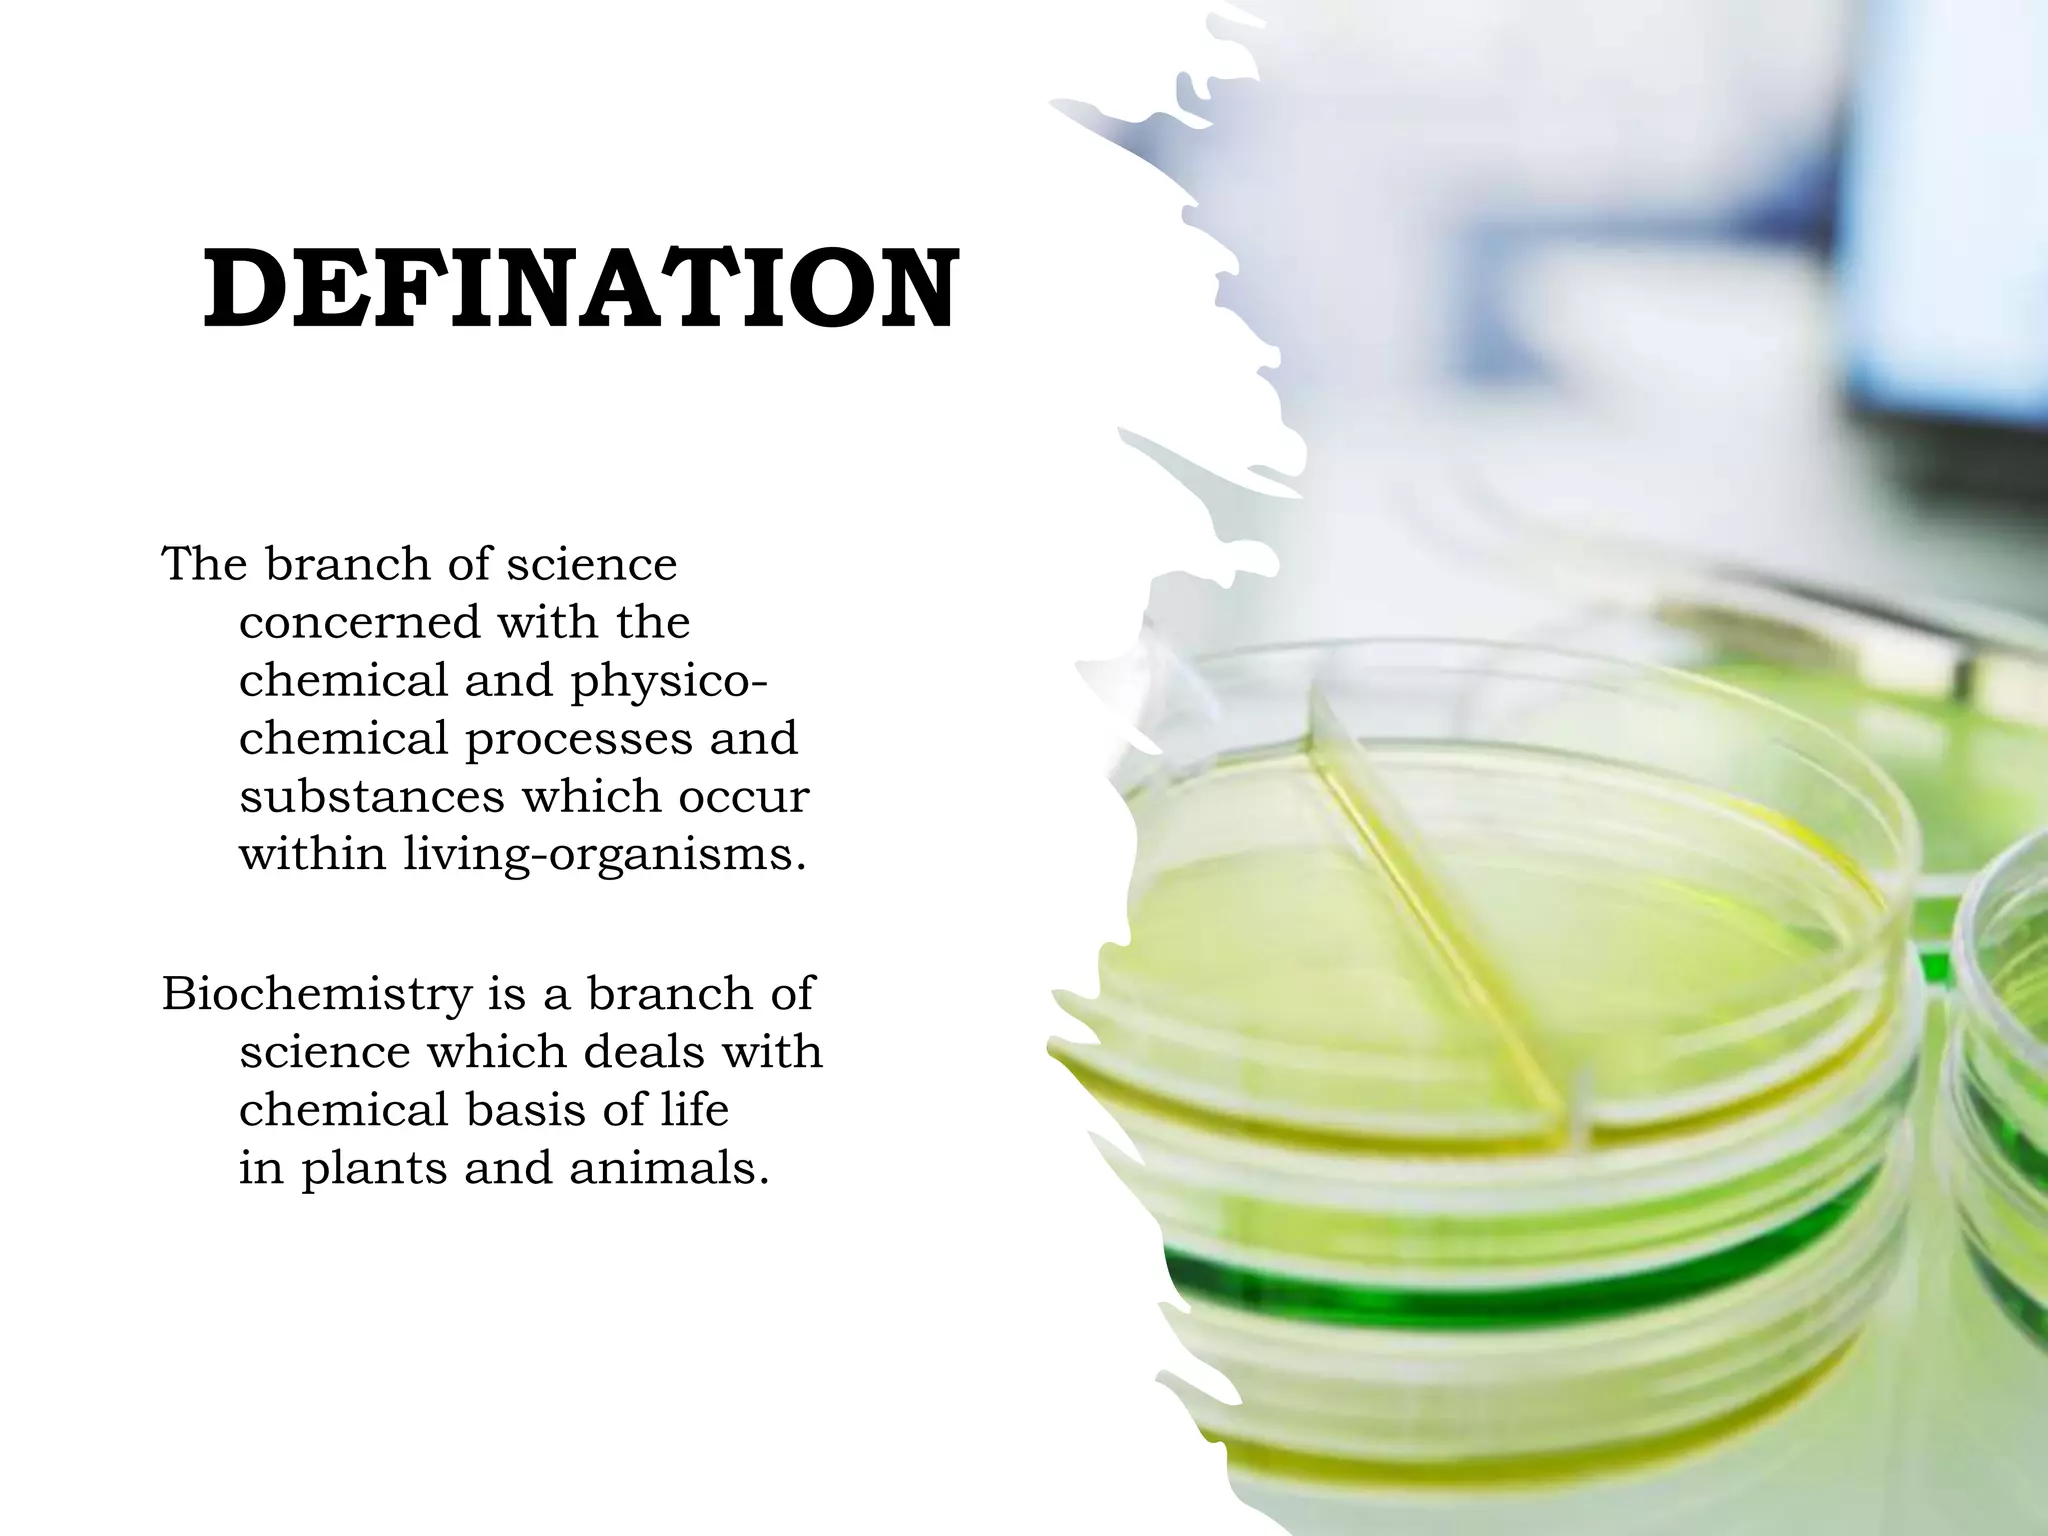
DEFINATION
The branch of science
concerned with the
chemical and physico-
chemical processes and
substances which occur
within living-organisms.
Biochemistry is a branch of
science which deals with
chemical basis of life
in plants and animals.

The document discusses the role of biochemistry in understanding the chemical processes within living organisms, including its applications in medicine and pharmacy. It highlights the significance of biochemistry in areas such as physiology, pathology, nutrition, and drug development, emphasizing how biochemical knowledge aids in disease diagnosis and drug stability. Additionally, it covers the structure and function of various cell components, including the nucleus, cytoplasm, and organelles like mitochondria and lysosomes.